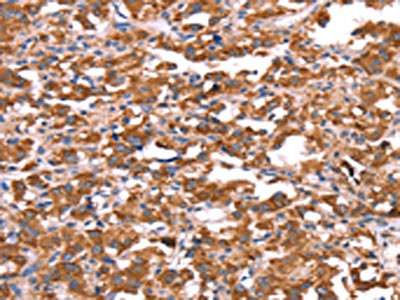

FXR1 Antibody
-
中文名稱:FXR1兔多克隆抗體
-
貨號:CSB-PA018431
-
規格:¥1100
-
圖片:
-
The image on the left is immunohistochemistry of paraffin-embedded Human thyroid cancer tissue using CSB-PA018431(FXR1 Antibody) at dilution 1/20, on the right is treated with synthetic peptide. (Original magnification: ×200)
-
The image on the left is immunohistochemistry of paraffin-embedded Human gastric cancer tissue using CSB-PA018431(FXR1 Antibody) at dilution 1/20, on the right is treated with synthetic peptide. (Original magnification: ×200)
-
-
其他:
產品詳情
-
Uniprot No.:
-
基因名:
-
別名:Fragile X mental retardation autosomal homolog 1 antibody; Fragile X mental retardation syndrome related protein 1 antibody; Fragile X mental retardation syndrome-related protein 1 antibody; FXR1 antibody; FXR1_HUMAN antibody; FXR1P antibody; hFXR1p antibody
-
宿主:Rabbit
-
反應種屬:Human,Mouse,Rat
-
免疫原:Synthetic peptide of Human FXR1
-
免疫原種屬:Homo sapiens (Human)
-
標記方式:Non-conjugated
-
抗體亞型:IgG
-
純化方式:Antigen affinity purification
-
濃度:It differs from different batches. Please contact us to confirm it.
-
保存緩沖液:-20°C, pH7.4 PBS, 0.05% NaN3, 40% Glycerol
-
產品提供形式:Liquid
-
應用范圍:ELISA,IHC
-
推薦稀釋比:
Application Recommended Dilution ELISA 1:1000-1:2000 IHC 1:25-1:100 -
Protocols:
-
儲存條件:Upon receipt, store at -20°C or -80°C. Avoid repeated freeze.
-
貨期:Basically, we can dispatch the products out in 1-3 working days after receiving your orders. Delivery time maybe differs from different purchasing way or location, please kindly consult your local distributors for specific delivery time.
-
用途:For Research Use Only. Not for use in diagnostic or therapeutic procedures.
相關產品
靶點詳情
-
功能:RNA-binding protein required for embryonic and postnatal development of muscle tissue. May regulate intracellular transport and local translation of certain mRNAs.
-
基因功能參考文獻:
- in head and neck squamous cell carcinoma, fragile X mental retardation syndrome related protein 1 (Fxr1) overexpression correlates with reduced F-box protein 4 (Fbxo4) levels. PMID: 29142209
- Inhibition of the remaining family member FXR1 selectively blocks cell proliferation in human cancer cells containing homozygous deletion of both TP53 and FXR2 in a collateral lethality manner. PMID: 28767039
- Our findings support our a priori hypothesis of a possible interaction between GSK3B (rs12630592 T allele) and FXR1 (rs496250 A allele) in mood disorder patients. PMID: 28242499
- human microbiota was able to reduce the levels of tauro-beta-muricholic acid and induce expression of FXR target genes Fgf15 and Shp in ileum after long-term colonization. We show that a human microbiota can change BA composition and induce FXR signaling in colonized mice, but the levels of secondary BAs produced are lower than in mice colonized with a mouse microbiota PMID: 27956475
- These data reveal a new role of FXR1 in controlling induction of monocyte migration. PMID: 27229378
- FXR1 binds and destabilizes p21 mRNA, binds and stabilizes TERC RNA and suppresses the cellular senescence in oral cancer cells. PMID: 27606879
- FXR1P interacts with CMAS, and that FXR1P may enhance the activation of sialic acid via interaction with CMAS, and increase GM1 levels to affect the development of the nervous system, thus providing evidence for further research into the pathogenesis of FXS. PMID: 27357083
- P97 interacts with 3' UTR-binding FXR1a-associated microRNPs and with PARN, which binds mRNA 5' caps, forming a specialized complex to translate recruited mRNAs in these altered canonical translation conditions. PMID: 26942679
- An accumulation of 8 SNPs in the fragile gene family (FMR1, FXR1 and FXR2)were found associated with autistic traits in a sample of male patients. PMID: 26612855
- FXR1P is a GSK3beta substrate with a role in regulating mood and emotion processing PMID: 26240334
- The mechanisms by which FXR1 executes its regulatory function by forming a novel complex with two other oncogenes, protein kinase C, iota and epithelial cell transforming 2, located in the same amplicon via distinct binding mechanisms, were identified. PMID: 25733852
- binding of PKP1/3 to FXR1 was RNA independent, and both PKP3 and FXR1 stabilized PKP2 mRNA. PMID: 25225333
- Deregulation of Fragile X-related protein 1 by the lipodystrophic lamin A p.R482W mutation elicits a myogenic gene expression program in preadipocytes. PMID: 24108105
- findings showed that FXR1P interacts with BTF in vivo and proved that FXR1P and BTF can co-localize mainly in the cytoplasm around the nucleus PMID: 24389646
- FXR1 and UPF1 may have a functional role in prostate cancer progression and metastasis. PMID: 23881279
- Our study describes a novel role of FXR1P that has crucial implications for the understanding of its role during myogenesis and muscle development PMID: 23555284
- Data show that the nuclear localization signals of the FXR1 and FXR2 comprise tandem Tudor domain architectures. PMID: 21072162
- These results indicate that FMR1 gene function is evolutionarily conserved in neural mechanisms and cannot be compensated by either FXR1 or FXR2, but that all three proteins can substitute for each other in non-neuronal requirements. PMID: 20442204
- Fxr1p shows a more tissue-specific expression particularly during late embryonic development. PMID: 15968590
- Results show that three genes, namely FXR1, CLAPM1 and EIF4G, are most frequently overexpressed in the center of the amplified domain in squamous cell carcinomas. PMID: 17290396
- A crosslinking-coupled affinity purification method was used to isolate TNF-alpha AU-rich element-associated proteins: two microRNP-related proteins, FXR1 and AGO2 were found that associate during translation activation. PMID: 17382880
- FXR1 mRNA splicing pattern is altered in facioscapulohumeral muscular dystrophy myoblasts. PMID: 18628314
- FXR1P and FXR2P KH2 domains bind G-quadruplex and kissing complex RNA with the same affinity as the FMRP KH2 domain. PMID: 19487368
顯示更多
收起更多
-
亞細胞定位:Cytoplasm, cytosol.
-
蛋白家族:FMR1 family
-
組織特異性:Expressed in all tissues examined including heart, brain, kidney and testis.
-
數據庫鏈接:
Most popular with customers
-
-
YWHAB Recombinant Monoclonal Antibody
Applications: ELISA, WB, IHC, IF, FC
Species Reactivity: Human, Mouse, Rat
-
Phospho-YAP1 (S127) Recombinant Monoclonal Antibody
Applications: ELISA, WB, IHC
Species Reactivity: Human
-
-
-
-
-